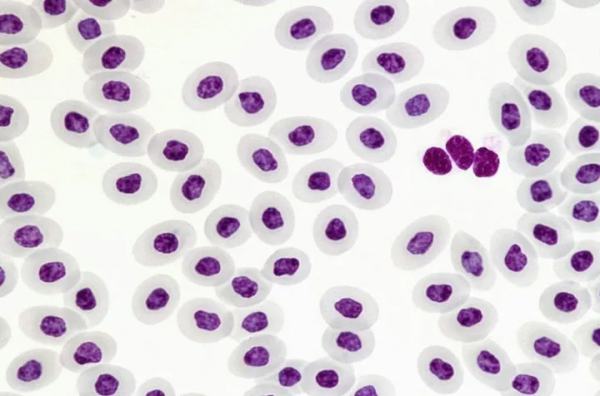
天能VE-586丨免疫組化、Elisa、wb的區別

Western Blot 樣品製備要加蛋白裂解液(含有蛋白酶抑制劑),然後冰上研磨,收集於EP管,冰上裂解30min,4度12000rpm離心15min,取上清分裝,即得到蛋白樣品。建議直接電泳,多餘的-80儲存。建議分裝的蛋白每支略多於一次上樣量,一次性用完一支,避免反覆凍融。
ELISA樣品,直接腦組織冰上勻漿,收集於EP管,同上一樣離心,大約220-250ul每支分裝(因為ELISA上樣量基本都是每孔100ul,做復孔,每個樣品2孔,就需要200ul,為了避免不夠2孔,分裝時要大於200ul每支),直接實驗。多餘的-80儲存,一樣避免反覆凍融。
不過ELISA最好少量樣品進行預實驗,或者查閱文獻,看看大概組織裡有多高濃度,選擇合適的試劑盒,測量範圍要與組織濃度相符。避免濃度過高測量不準,或者濃度過低,小於試劑盒最低可測濃度。
一、目的
雖然兩者都是透過抗原抗體反應對蛋白質進行檢測,WB主要還是定性,Elisa可以定性,也可以定量。
WB所檢測的一般是抗原,而Elisa抗原抗體都可以檢測。
WB所檢測的抗原可以知道其分子量的大小,或是否是多聚體、降解產物等,一句話,WB可以確定所用抗體是與那種蛋白起作用的;而Elisa無能為力,一鍋端了。
二、模式
WB是(抗原-抗體-二抗酶)模式進行檢測;Elisa模式有多種,如(抗原-抗體-二抗酶)、(抗原-抗體-抗原酶)、(抗抗體-抗體-抗原酶)、(抗體-抗原-抗體酶)、(抗抗體-抗體-抗原-抗體酶)等等很多很多。
三、抗體的適用性
WB所適用的一抗一般是線性位點的,ELISA線性或構象型抗體都可以使用。從另一個意義上講,WB可以做抗體是線性位點還是構象型位點的補充判定,而Elisa不行。
四、靈敏度
一般Elisa的靈敏度要遠高於WB,這從一般酶標記物的使用濃度或待檢樣品的稀釋度上就可以看出。
五、可操作性
WB一次處理量就是一塊膠版,10-20個樣品最多了。Elisa一塊96孔板一次可以處理96個樣本,可以設定多個復孔、對照、梯度樣等來提高檢測的可信度。
WB操作常見的非特異性條帶,膜本底差,顯色不好等等缺點在Elisa上表現得要好得多。
六、商品化度
WB不管怎樣,都要自己先做電泳。而Elisa有很多成熟的商品化試劑盒了,只要不怕花錢,檢測要方便快捷得多。
樣本處理和染色方法
1 懸浮細胞的染色:將正常培養和誘導凋亡的懸浮細胞(0.5~1×106)用PBS洗2次,加入100ul Binding Buffer和FITC標記的Annexin-V(20ug/ml)10ul,室溫避光30min,再加入PI(50ug/ml)5ul,避光反應5min後,加入400ul Binding Buffer,立即用FACScan進行流式細胞術定量檢測(一般不超過1h), 同時以不加AnnexinV-FITC及PI的一管作為陰性對照。
2 貼壁培養的細胞染色:先用0.25%的胰酶消化,洗滌、染色和分析同懸浮細胞。
3 爬片細胞染色:同上,最後用熒光顯微鏡和共聚焦鐳射掃描顯微鏡進行觀察。
VE-586 轉移電泳槽是用來對少量核酸及蛋白質樣品進行轉移電泳的裝置
操作簡便,方便環保
創新設計,同時可 以轉印四塊凝膠
做到一槽多用,可節省實驗空間和經費
效能特點
槽體採用高強度和高透明度的聚碳酸酯材料注塑成型,免除液體滲漏的困擾。
專用開啟式轉移膠架,操作方便。
可同時轉印四塊9×9cm凝膠
專用藍冰盒可反覆使用,方便環保。
轉印時間為15-60min,也可選擇低電壓過夜。
具體課程介紹詳見後文或戳圖片連結
#後續會有更多幹貨哦#